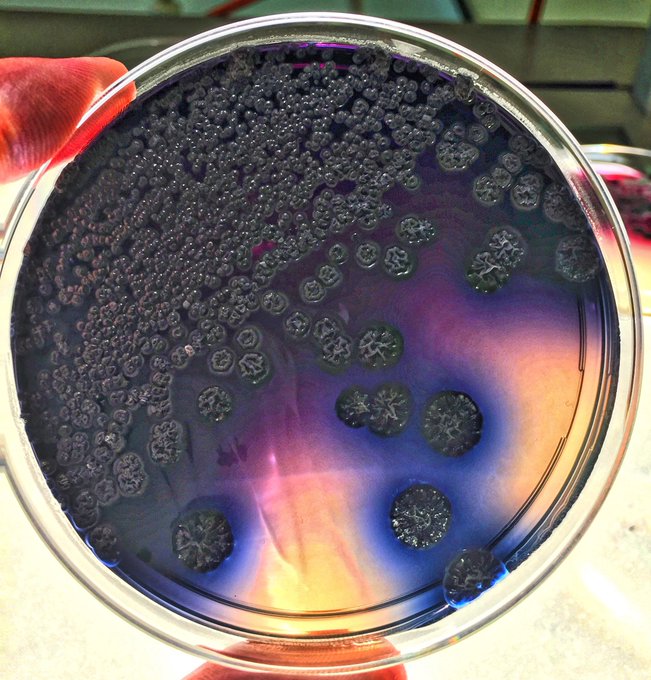

12 件中 11〜12件を表示
A cross section of the fungal conduit that acts as the internet for plants: https://t.co/YOCSe7j6dW
1
8